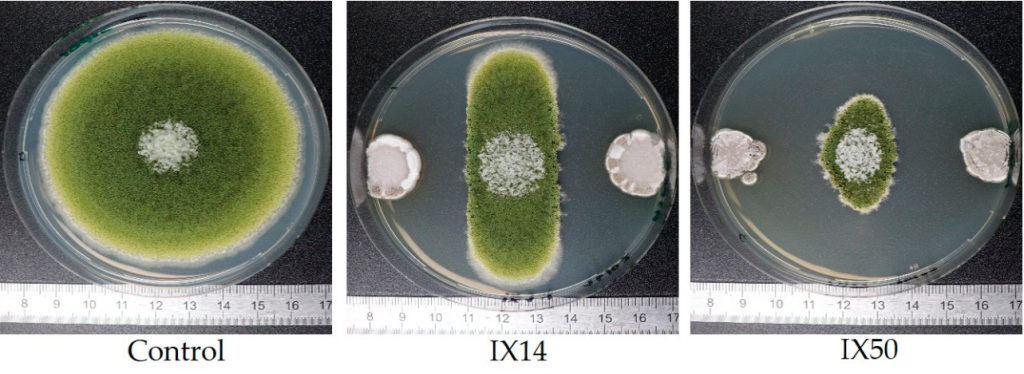

Streptomyces Bacteria Offer a Natural Defense Against Toxic Aflatoxins
This study published in Toxins (MDPI) reveals that Streptomyces bacteria—best known for producing antibiotics—also have remarkable antifungal and detoxifying properties that could revolutionize food safety. Researchers from the University of Montpellier investigated 59 Streptomyces isolates and found that most were able to inhibit the growth of the fungus Aspergillus flavus and significantly degrade aflatoxin B1 (AFB1), a potent carcinogenic toxin often found in stored grains.
Why Aflatoxin B1 Matters
Aflatoxin B1 is one of the most harmful mycotoxins, produced by Aspergillus flavus under warm and humid storage conditions. Even at microgram levels, AFB1 poses severe risks to human and animal health, including liver cancer and immune suppression. Existing chemical or physical decontamination methods are costly and can reduce food quality—creating a strong need for safe, biological alternatives.
Bacterial Warriors Against Fungal Invaders
In laboratory tests, 58 of the 59 Streptomyces strains were able to suppress A. flavus growth, with the best-performing isolate reducing fungal development to just 13% of the untreated control. In addition, aflatoxin B1 levels dropped by up to 99%, showcasing the bacteria’s dual antifungal and detoxifying power.
The study also compared whole bacterial cells with cell-free extracts (CFEs)—liquid portions containing bacterial enzymes. While CFEs were less potent overall, several extracts still achieved up to 60% toxin reduction, confirming the role of extracellular enzymes in aflatoxin biodegradation.
How the Detoxification Works
Chemical analysis revealed that Streptomyces enzymes likely break down AFB1 by altering its lactone and difuran rings—transforming the toxin into less harmful molecules. Strains such as Streptomyces griseoviridis (commercially known as Mycostop®) and isolate IX20 achieved near-total AFB1 degradation, while also reducing genotoxicity by more than 68%, as shown by the SOS chromotest assay.
Implications for Agriculture and Food Safety
The findings highlight the potential of Streptomyces as a biological control agent for managing fungal contamination in grains, nuts, and other crops. Unlike synthetic fungicides, these bacteria offer a sustainable and eco-friendly approach to post-harvest protection. Their enzyme systems could even be harnessed for industrial detoxification of contaminated food batches.
Researchers emphasize that understanding the exact mechanisms—especially the enzymes responsible for aflatoxin degradation—could pave the way for commercial bioprotective formulations and natural decontamination processes in food supply chains.
Key Takeaway
Streptomyces bacteria represent a promising natural solution to one of agriculture’s most persistent challenges: safeguarding food from aflatoxin contamination without compromising safety or sustainability.
Reference
Campos-Avelar, I., Colas De La Noue, A., Durand, N., Cazals, G., Martinez, V., Strub, C., Fontana, A., & Schorr-Galindo, S. (2021). Aspergillus flavus growth inhibition and aflatoxin B1 decontamination by Streptomyces isolates and their metabolites. Toxins, 13(5), 340.






